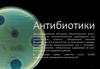
Противомикробные препараты антибиотики

Похожие презентации:
Антибиотики. Классификация антибиотиков
1.
Тема: Антибиотики.Методы определения
чувствительности к антибиотикам.
Сокращения:
БГСА – β–гемолитический стрептококк группы А (S.pyogenes)
MRSA – метициллинорезистентный S.aureus
PRSA – пенициллинорезистентный S.aureus
БЛРС – β–лактамазы расширенного спектра
ГОБ – гематоофтальмический барьер
ГЭБ – гематоэнцефалический барьер
Т1/2 – период полувыведения
2. КЛАССИФИКАЦИЯ АНТИБИОТИКОВ
• По происхождению:Способ получения
Продуцент
Примеры
Собственно бактерии
Грамицидин
полимиксин
Актиномицеты
Грибы
Стрептомицин,
эритромицин,
тетрациклины и др.
Бензилпенициллин,
цефалоспорины,
фузидиевая кислота
Оксациллин,
ампициллин,
гентамицин,
рифампицин и др.
Природные
(биосинтетические)
Полусинтетические
(комбинация
биосинтеза и
химического синтеза
Продукты модификации
молекул природных
антибиотиков
Синтетические
Аналоги
природных
антибиотиков,
синтезированных
химическим путем
С,
Левомицетин, амикацин
3. КЛАССИФИКАЦИЯ АНТИБИОТИКОВ
По спектру антимикробной
активности:
Антибактериальные
Противогрибковые
Антипротозойные
• По типу действия:
бактерицидные - необратимо
связываются с клеточными
мишенями, вызывая гибель
чувствительных к ним
микроорганизмов.
бактериостатические ингибируют рост и размножение
микробных клеток, но при
удалении антибиотика
жизнедеятельность возбудителей
восстанавливается
4. КЛАССИФИКАЦИЯ АНТИБИОТИКОВ
По спектру действия:1) с преимущественным действием на грамположительные
микроорганизмы (линкозамиды, биосинтетические пенициллины,
цефалоспорины 1-го поколения, макролиды, ванкомицин, линкомицин);
2) с преимущественным действием на грамотрицательные
микроорганизмы (монобактамы, циклические
полипептиды,цефалоспорины 3-го поколения);
3) широкого спектра действия (аминогликозиды, левомицетин,
тетрациклины, полусинтетические пенициллины широкого спектра
действия (ампициллин, азлоциллин и др.) и цефалоспорины 2-го
поколения).
4) Противотуберкулезные антибиотики (стрептомицин, рифампицин,
флоримицин).
5) Противогрибковые антибиотики (нистатин, леворин, гризеофульвин,
амфотерицин В, кетоконазол, анкотил, дифлюкан и др.).
5.
6. КЛАССИФИКАЦИЯ АНТИБИОТИКОВ
выделяют антибиотики первой очереди (пенициллины,макролиды, аминогликозиды), второй очереди (цефалоспорины,
полусинтетические аминогликозиды, аугментин и пр.) и
резервные (фторхинолоны, карбопенемы).
Выделяют антибиотики короткого и пролонгированного
действия. Так, для поддержания бактерицидной концентрации в
плазме пенициллин следует вводить каждые 4 часа, а роцефин
(цефалоспорин 3 поколения) - 1 раз в сутки.
По токсичности разделяют ото-, нефро-, гепато-,
нейротоксичные и т. д.
Выделяют антибиотики со строго регламентированной дозой
применения (линкозамины, аминогликозиды и пр.) и препараты,
дозу которых можно увеличивать в зависимости от
выраженности инфекционного процесса (пенициллины,
цефалоспорины).
7. КЛАССИФИКАЦИЯ АНТИБИОТИКОВ ПО МЕХАНИЗМУ ДЕЙСТВИЯ
Ингибиторы синтеза клеточной стенки.Ингибиторы синтеза белка на рибосомах.
Ингибиторы синтеза нуклеиновых кислот
Нарушение функционирования ЦПМ
Нарушение обменных процессов (синтеза
фолиевой кислоты)- сульфаниламиды,
триметоприм, изониазид
Механизм действия большинства антибиотиков основан
на ингибировании жизненно важных ферментов
8.
Ингибиторы синтеза белкаИнгибиторы синтеза клеточной стенки
b-лактамы: (ингибируют
Аминогликозиды: 30S
поперечную сшивку
пептидогликана)
стрептомицин, тобрамицин, канамицин,
амикацин (аминосахара)
Пенициллины (оксациллин –
Макролиды:
эритромцин
(14), кларитромицин, азитромицин (15)
антистафиококк; ампициллинрасширен.спектр).
50S
Тетрациклины: (4 кольца) 30S
Цефалоспорины (цефепим,
тетрациклин, доксицклин
цефтриаксон)
Хлорамфеникол (левомицетин) 50S
Карбапенемы (имипенем,
меропенем)
Оксазалидиноны:
линезолид
(предотвращает образование 70S
комплекса)
Монобактамы (азтреонам)
Гликопептиды: (ванкомицин-
нарушение синтеза пептидогликана
за счёт связывания с фрагментом DAla-D-Ala)
Линкозамиды: 50S клиндамицин,
линкомицин
Даптомицин
Ингибиторы синтеза ДНК, РНК
ДНК – фторхинолоны:
Ципрофлоксацин, офлоксацин,
левофлоксацин, моксифлоксацин
РНК - рифамицины : рифампицин
Ингибиторы функции ЦПМ
Полимиксины: полимиксин В, М
Полиены: нистатин, амфотерицин В
Имидазолы: кетоконазол,клотримазол
9.
b-лактамы ингибируютпоперечную сшивку
пептидогликана
Хинолоны ингибируют
ДНК-гиразу и
топоизомеразу IV
Гликопептиды нарушают синтез
пептидогликана за счёт связывания
с фрагментом D-Ala-D-Ala)
ингибируют синтез
фолиевой к-ты
Связывание с 50S субъединицей
нарушает перемещение пептидной
цепи и транслокацию рибосомы
Связывание с 30S субъединицей усиливает
связывание т-РНК и приводит к включению в
полипептидную цепь неправильных амк-т
10.
11.
Ингибиторы синтеза клеточной стенки12.
β-Лактамные антибиотикиβ-Лактамные антибиотики ингибируют:
• транспептидазу пептидогликана, что приводит
к нарушению его образования;
• эндогенный ингибитор, что приводит к
активации муреингидролазы, расщепляющей
пептидогликан.
Мишенью β-Лактамных антибиотиков
являются ферменты, осуществляющие
перекрестную сшивку пептидогликана
β -Лактамные антибиотики малотоксичны для
макроорганизма, так как мембраны клеток
человека не содержат пептидогликан.
Антибиотики этой группы эффективны
преимущественно в отношении делящихся, а
не покоящихся клеток, поскольку в клетках,
находящихся в стадии активного роста, синтез
пептидогликана происходит наиболее
интенсивно.
Пенициллины
(оксациллин –
антистафиококк;
ампициллинрасширен.спектр).
Цефалоспорины
(цефепим, цефтриаксон)
Карбапенемы
(имипенем, меропенем)
Монобактамы
(азтреонам)
13. Пенициллины
ПриродныеБензилпенициллин (пенициллин)
Бензилпенициллин прокаин
Бензатин бензилпенициллин
Феноксиметилпенициллин
Бензатин феноксиметилпенициллин
Полусинтетические
Антистафилококковые
Оксациллин
Расширенного спектра
Аминопенициллины
Антисинегнойные
Карбоксипенициллины
Ампициллин
Амоксициллин
Карбенициллин
Тикарциллин
Уреидопенициллины
Азлоциллин
Пиперациллин
Ингибиторозащищенные
Амоксициллин/клавуланат
Ампициллин/сульбактам
Тикарциллин/клавуланат
Пиперациллин/тазобактам
Комбинированные
Ампициллин/оксациллин
14. АНТИСТАФИЛОКОККОВЫЕ ПЕНИЦИЛЛИНЫ
• ОКСАЦИЛЛИН• Спектр активности
В отличие от других антибиотиков группы пенициллина устойчив к действию
пенициллиназы (из группы β-лактамаз), которую продуцируют 80-90%
штаммов S.aureus. В этом заключается основное клиническое значение
препарата. В остальном антибактериальный спектр такой же, как у
пенициллина, но степень активности значительно меньше.
Следует учитывать, что в стационарах, особенно в ОРИТ, распространены
штаммы S.aureus, устойчивые к оксациллину (метициллину*). Они известны
под названием MRSA (methicilline-resistant S.aureus) и характеризуются
полирезистентностью.
*Метициллин - первый пенициллиназоустойчивый пенициллин. Снят с
производства ввиду отсутствия преимущества перед оксациллином, но
термин MRSA сохраняется.
15. Цефалоспорины. Классификация
Цефалоспорины I поколенияПарентеральные
П/о
Цефалоспорины II поколения
Парентеральные
П/о
Цефалоспорины III поколения
Парентеральные
Цефазолин
Цефалексин
Цефуроксим
Цефуроксима аксетил
Цефаклор
Цефотаксим
Цефтриаксон
Цефоперазон
Цефаперазона/сульбактам
Цефтазидим
П/о
Цефиксим
Цефтибутен
Цефалоспорины IV поколения
Парентеральные
Цефепим
Цефпиром
Цефалоспорины V поколения
Парентеральные
Цефтобипрола медокарил
Цефтаролин фосамил
16. ЦЕФАЛОСПОРИНЫ
Сравнительная антимикробная активность цефалоспориновАктивность в отношении
Стабильность к бета-лактамазам
Поколения
цефалоспоринов Грам+
бактерий
Грамбактерий
стафилококков
грамотрицательных
бактерий
Первое
+++
+/-
++
-
Второе
++
+
++
+/-
Третье
+
+++
+
+
Четвертое
++
+++
++
++
В ряду от I к V поколению для цефалоспоринов характерна тенденция к расширению
спектра действия и повышению уровня антимикробной активности в отношении
грамотрицательных бактерий при некотором понижении активности в отношении
грамположительных микроорганизмов.
17.
18. ЦЕФАЛОСПОРИНЫ V поколения
Цефтобипрол обладает уникальной для β-лактамов активностью в отношенииметициллинорезистентных штаммов S. Aureus;
бактерицидной активностью в отношении широкого спектра патогенов —
грамположительных возбудителей: S. aureus и коагулазонегативных
стафилококков, S. pneumoniae, E. faecalis, включая штаммы, резистентные
к традиционно применяемым антибиотикам; грамотрицательных
патогенов: H. influenzae, энтеробактерий (кроме штаммов, продуцирующих беталактамазы расширенного спектра действия — БЛРС), некоторых
изолятов P. aeruginosa.
Расширение спектра активности в сравнении с цефалоспоринами I-IV поколений
достигается за счёт значительного повышения аффинности молекулы
цефтобипрола к пенициллиносвязывающим белкам (ПСБ), включая ПСБ-2а,
характерный для метициллинорезистентных стафилококков.
Цефтаролин фосамил активен в отношении метициллин-
резистентного золотистого стафилококка (MRSA) и нечувствительных к
пенициллину пневмококков (PNSP) за счет сродства к измененным пенициллинсвязывающим белкам, обнаруженных у этих организмов.
ЦЕФОПЕРАЗОН/СУЛЬБАКТАМ (Сульперазон)
-цефоперазон + ингибитор β-лактамаз сульбактам
-единственный ингибиторозащищенный цефалоспорин.
В отличие от других цефалоспоринов хорошо действует на B.fragilis и другие неспорообразующие
анаэробы, поэтому при инфекциях брюшной полости и малого таза может применяться в виде
монотерапии.
-
19. ГЛИКОПЕПТИДЫ
Ванкомицин, тейкопланин,и липогликопептиды: телаванцин, оритаванцин, далбаванцин,
• В отличие от бета-лактамных антибиотиков, гликопептидные препараты
связываются не с PBP, а с их субстратом.
Они присоединяются к концевым остаткам D-аланил-D-аланина в пептидных
хвостах, блокируя поперечную сшивку пептидогликана.
Также в результате данного связывания может нарушаться целостность
мембраны и ингибироваться формирование гликозидных связей между
мономерами пептидогликана.
Гликопептидные антибиотики действуют только на грамположительные
микроорганизмы.
Данные препараты не всасываются через ЖКТ, и для системного применения они
вводятся внутривенно с помощью капельницы.
Данная группа препаратов характеризуется нефротоксичностью,
ототоксичностью, может вызывать тромбофлебиты.
Поэтому системное использование гликопептидных антибиотиков чаще всего
ограничивается терапией инфекций, вызванных метициллин-резистентными
золотистыми стафилококками (MRSA) – представителями вида Staphylococcus
aureus, характеризующимися нечувствительностью практически ко всем беталактамным антибиотикам.
20. Механизм действия липогликопептидов
• Липид II осуществляет транспортпредшественника пептидогликана
А.Оритаванцин связывается с растущим участком
пептидогликана
В. Гидрофобный «хвост» антибиотика встраивается мембрану
С. Антибиотик свзывается с D-аланил-D-аланином
21. Отдельные ингибиторы синтеза пептидогликана
• Циклосерин- конкурентный антагонист D-аланина• обладает широким спектром антибактериального
действия: угнетает грамположительные и
грамотрицательные бактерии.
• рассматривается как «резервный»
противотуберкулезный препарат, то есть
назначаемый больным хроническими формами
туберкулеза, у которых ранее применявшиеся
основные препараты перестали оказывать эффект.
• Фосфомицин- является структурным аналогом
фосфоенола пирувата, вступает в конкурентное
взаимодействие с ферментом N-ацетил-Dглюкозамино-3-о-енолпирувил-трансферазой.
• Активен в отношении многих грам+ и грам- бактерий
• снижает адгезию ряда бактерий на эпителии
мочевыводящих путей
22. Ингибиторы синтеза миколовых кислот
• являются по химической структуре производнымиизоникотиновой кислоты,
широко используются для лечения туберкулёза и
других инфекций, вызванных представителями
рода Mycobacterium.
Данные препараты после попадания в
бактериальную клетку подвергаются
восстановлению различными ферментами,
в результате образуются свободно-радикальные
формы данных веществ.
Они входят в активный центр еноил-редуктазы,
участвующей в синтезе миколовых кислот, и
ковалентно связываются с кофактором NADH,
ингибируя данный фермент.
Примерами данной группы препаратов являются
изониазид, этионамид, протионамид.
Строение клеточной стенки
микобактерий
23. Этамбутол
• Ингибитор синтеза арабиногалактана• Противотуберкулезный препарат.
• Этамбутол активен в отношении
M.tuberculosis (включая их штаммы,
устойчивые к стрептомицину,
канамицину, изониазиду, ПАСК и
этионамиду), а также ряда атипичных
микобактерий (M.kansasii, M.avium,
M.xenopi).
24.
25.
Ингибиторы синтеза белка26.
27. АМИНОГЛИКОЗИДЫ
I поколениеСтрептомицин
Неомицин
Канамицин
II поколение
Гентамицин
Тобрамицин
Нетилмицин
III поколение
Амикацин
• Присоединяются к 30S субъединице и стабилизируют неправильное кодон-
антикодоновое связывание, в результате чего повышается вероятность включения
ошибочных аминокислот в растущую полипептидную цепь.
• Это приводит к накоплению в бактериальных клетках белковых молекул, не способных
принять правильную конформацию
• Активны в отношении грам• Микобактерии: M.tuberculosis (стрептомицин, канамицин и амикацин).
• Анаэробы устойчивы, ! Пневмококки устойчивы
Нежелательные реакции
• Ототоксичность (вестибулотоксичность, кохлеатоксичность).
• Нефротоксичность.
• Нервно-мышечная блокада.
Лекарственные взаимодействия
• Синергизм при сочетании с пенициллинами или цефалоспоринами (но не при введении в
одном шприце!).
• Антагонизм с β-лактамными антибиотиками и гепарином при смешивании в одном
шприце вследствие физико-химической несовместимости.
• Усиление токсических эффектов при сочетании с другими нефротоксичными и
ототоксичными препаратами (полимиксин В, амфотерицин В, фуросемид и др.).
Тобрамицин
Амикацин
28. ТЕТРАЦИКЛИНЫ
- связываются с 30S субъединицей бактериальных рибосом, нарушаяприсоединение тРНК.
К группе тетрациклинов относятся природный тетрациклин и полусинтетические
препараты доксициклин (Вибрамицин, Юнидокс солютаб ) и миноциклин.
Общие свойства
• Бактериостатическое действие.
• Очень широкий спектр активности, но высокий уровень вторичной резистентности
многих бактерий.
• Перекрестная устойчивость микроорганизмов ко всем препаратам группы.
• Высокая частота нежелательных реакций.
Нежелательные реакции
• Общее катаболическое действие, угнетение белкового обмена, гиперазотемия.
• Диспептические явления, эзофагит.
• Угнетение нормальной микрофлоры ЖКТ и влагалища; суперинфекции, включая кандидоз
ЖКТ и влагалища.
• У детей нарушение образования костной и зубной ткани: изменение окраски зубов,
дефекты эмали, замедление продольного роста костей.
• Фотосенсибилизация (чаще доксициклин).
• Гепатотоксичность, вплоть до некроза тканей печени - особенно при патологии печени и
быстром внутривенном введении.
• Синдром псевдоопухоли мозга: повышение внутричерепного давления при длительном
приеме.
• Нефротоксичность: развитие тубулярного некроза при использовании просроченных
препаратов.
29. Глицилциклины
• Тигециклин – первый антибиотик нового класса• Глицилциклины – полусинтетические АМП, имеющие структурное родство с
тетрациклинами
• Способны преодолевать 2 основных механизма резистентности к
тетрациклинам: «защита рибосом» и эффлюкс
• В связи с этим обладает более широким спектром антимикробной активности
• Бактериостатик, но в отношении некоторых м/о действует бактерицидно
• Тигециклин обратимо связывается с определенным участком 30S
субъединицы, предотвращая доступ аминоацил-т-РНК и присоединение амкты к пептидной цепи
• Тигециклин связывается с особым спиральным регионом А-участка
рибосомы, что обеспечивает уникальный механизм действия и способность
преодолевать механизмы резистентности к тетрациклинам
30. Глицилциклины
• Осложнения те же, что у тетрациклинов31. МАКРОЛИДЫ
14-членные15-членные (азалиды)
Эритромицин
Олеандомицин
Спирамицин
Джозамицин
Мидекамицин
Рокситромицин
Кларитромицин
16-членные
Природные
Полусинтетические
Азитромицин
Мидекамицина ацет
- связываются с 50S субъединицей бактериальной рибосомы в области туннеля
для пептидной цепочки, ингибируя её удлинение. Вследствие низкой токсичности
макролиды наряду с бета-лактамами являются одними из основных
антибактериальных препаратов, используемых в современной клинической
практике.
32. ЛИНКОЗАМИДЫ
В данную группу входят линкомицин и клиндамицин.- связываются в пептидил-трансферазном центре 50S субъединицы
бактериальной рибосомы, ингибируя каталитическую активность и
прекращая синтез пептидной цепочки.
- Обычно их используют для подавления роста грамотрицательных
анаэробных бактерий (например, представителей рода Bacteroides).
- Применение данной группы препаратов часто приводит к развитию
антибиотик-ассоциированных диарей, возникающих за счёт активного
размножения Clostridium difficile, вызванного подавлением нормальной
микрофлоры кишечника.
Общие свойства
• Бактериостатическое действие.
• Узкий спектр активности: грамположительные кокки и неспорообразующие
анаэробы.
• Перекрестная устойчивость микрофлоры к обоим препаратам.
• Высокие концентрации в костях и суставах.
• Плохое проникновение через ГЭБ.
• Отсутствие перекрестной аллергии с β-лактамами.
• Относительно частое развитие антибиотико-ассоциированной (C.difficileассоциированной) диареи.
33. ОКСАЗОЛИДИНОНЫ
ЛИНЕЗОЛИДТИДЕЗОЛИД
Зивокс
• механизм действия связан с ингибированием активности пептидилтрансферазного центра 50S субъединицы рибосомы
• Обладает преимущественно бактериостатическим эффектом и узким
спектром активности.
• Главное клиническое значение линезолида заключается в действии на
грамположительные кокки, устойчивые ко многим другим антибиотикам, в
том числе на MRSA, пенициллинорезистентные пневмококки и
ванкомицинорезистентные энтерококки.
• Наличие внутривенной и пероральной лекарственных форм позволяет
использовать линезолид для ступенчатой терапии.
ХЛОРАМФЕНИКОЛ
Левомицетин
Механизм действия тот же
•Имеет широкий спектр активности.
•На пневмококк, менингококк и гемофильную палочку действует
бактерицидно,
•на другую чувствительную микрофлору бактериостатически.
•Применяется ограниченно из-за тяжелых нежелательных реакций и
вторичной резистентности многих возбудителей.
34.
• Мупироцин (Бактробан, Бондерм) —антибактериальное и бактерицидное средство
широкого спектра действия для наружного
применения.
• ингибирует изолейцил-тРНК-синтазу,что
нарушает синтез белка
• Фузидиевая кислота ингибирует фактор
элонгации G, обеспечивающий перемещение
рибосомы по мРНК
• Важная особенность фузидиевой кислоты и её
солей — способность проникать в костную ткань
• Препараты группы стрептограминов -
комбинации из двух веществ, синергично
ингибирующие пептидил-трансферазный центр.
35.
Ингибиторы синтеза ДНК, РНК36. ХИНОЛОНЫ / ФТОРХИНОЛОНЫ
I поколение нефторированныеII поколение «грамотрицательные»
III поколение «респираторные»
IV поколение «респираторные»+
«антианаэробные»
Налидиксовая
кислота
Оксолиновая
кислота
Ципрофлоксацин
Норфлоксацин
Офлоксацин
Пефлоксацин
Ломефлоксацин
Спарфлоксацин
Левофлоксацин
Моксифлоксацин
• Механизм действия – ингибирование
ферментов бактериальной клетки – ДНКгиразы и топоизомеразы IV;
чрезвычайно высокая степень
бактерицидной активности в отношении
большинства чувствительных к ним
микроорганизмов;
уничтожение возбудителей инфекционных
заболеваний с минимальным
высвобождением различных компонентов
бактериальной клетки (эндотоксинов),
широкий спектр антимикробного действия
высокая биодоступность при приеме внутрь
пролонгированный период полувыведения
37.
38.
ФХ третьего и четвёртого поколения, в отличие от ФХ второго поколения,блокируют ещё одну «мишень»– топоизомеразу 4.
Функция этих ферментов заключается в следующем: они разрывают двойную
спираль ДНК, проносят через разрыв другой участок двойной спирали ДНК,
после чего обратно соединяют молекулу.
К основным бактериальным топоизомеразам II класса относят ДНК-гиразу
(фермент, который обеспечивает поддержание отрицательной
суперспирализации) и топоизомеразу IV (фермент, обеспечивающий
разделение сцепленных молекул и узлов ДНК).
Фторхинолоны связываются с топоизомеразами II класса в состоянии, когда
спираль ДНК разорвана, и стабилизируют данное состояние, препятствуя
обратному сшиванию ДНК.
Внесение множественных двухцепочечных разрывов в ДНК препятствует
выполнению всех её функций и ведет к гибели бактериальной клетки.
39. Нитроимидазолы Метронидазол.
• Механизм действия схож с механизмом токсичности O2.• Молекулы данных препаратов способны перехватывать
электроны с клеточных белков, превращаясь в свободные
радикалы и повреждая ДНК клетки.
• Метронидазол обладает активностью против анаэробных и
микроаэрофильных бактерий (например, Bacteroides fragilis и
Helicobacter pylori), а также некоторых анаэробных простейших
(например, Trichomonas vaginalis и Giardia lamblia).
40. Рифамицины
• связываются с бета-субъединицей РНК-полимеразыбактерий, блокируя синтез РНК.
• Основные препараты данной группы – рифампицин, рифабутин,
рифапентин – преимущественно используются для лечения
туберкулеза и других инфекций, вызванных микобактериями.
• Антибиотик рифаксимин, обладающий низкой всасываемостью в
ЖКТ, используется для лечения кишечных инфекций.
Нежелательные реакции
• гепатотоксичность (вплоть до развития гепатита);
• гематотоксичность: тромбоцитопения, гемолитическая анемия;
• гриппоподобный синдром (лихорадка, артралгия, миалгия). Чаще развивается при
возобновлении приёма препарата после перерыва в лечении.
Показания
• Основное - туберкулёз, при котором рифампицин применяется обязательно в сочетании с
изониазидом и другими противотуберкулёзными препаратами.
• Профилактика и лечение атипичных микобактериозов у ВИЧ-инфицированных пациентов
(в сочетании с азитромицином, кларитромицином и др.).
41.
Ингибиторы функции ЦПМ42. ПОЛИМИКСИНЫ
• это группа антибиотиков, механизм действиякоторых заключается в связывании с
липополисахаридом наружной мембраны
грамотрицательных бактерий и
последующем нарушении целостности
наружной и цитоплазматической мембран.
• Препараты данной группы в основном
применяются местно вследствие высокой
нефро- и нейротоксичности. (полимиксин В,
полимиксин М)
• Антибиотик колистин (также обозначаемый
как полимиксин Е) используется системно как
препарат резерва для лечения инфекций,
вызванных грамотрицательными бактериями
со множественной лекарственной
устойчивостью.
43. Даптомицин - первый представитель нового класса антибиотиков
Механизм действия даптомицина отличается от такового увсех известных на сегодняшний день антибиотиков.
Молекула представляет собой циклический липопептид,
состоящий из 13 аминокислотных остатков, имеющий
гидрофильное ядро и гидрофобный хвост.
Гидрофобный хвост посредством кальций-зависимого механизма
необратимо связывается с клеточной мембраной грам(+)
бактерий.
Формируется канал, приводящий к быстрой деполяризации
клеточной мембраны из-за выхода калия и, возможно, других
ионов, содержащихся в цитоплазме.
В результате грубого нарушения процессов синтеза
макромолекул наступает гибель бактериальной клетки.
В отличие от бета-лактамных антибиотиков, бактерицидное
действие даптомицина не связано с разрушением клетки.
44.
Антифолаты• Сульфаниламиды:
• препараты короткого действия (стрептоцид, норсульфазол, этазол,
сульфадимезин и др.);
• среднего действия (сульфазин и др.);
• длительного действия (сульфапиридазин, сульфадиметоксин и др.);
• сверхдлительного действия (сульфален и др.).
• Механизм действия - ингибирование дигидроптероатсинтазы – фермента,
который участвует в биосинтезе фолиевой кислоты, являющейся важнейшим
кофактором при синтезе пуриновых и пиримидиновых азотистых оснований.
• Схожим по строению и механизму действия является противолепрозный
препарат дапсон.
• Триметоприм - ингибирует бактериальную
дигидрофолат-редуктазу
• Триметоприм и сульфаметоксазол блокируют два
раздельных этапа пути биосинтеза фолатов.
• При совместном их применении антибактериальные
эффекты часто являются синергичными и бактерицидными.
• Ко-тримоксазол = сульфаметоксазол+триметоприм
• Ещё одним ингибитором синтеза фолиевой кислоты служит
противотуберкулезный препарат пара-аминосалициловая
кислота (ПАСК).
45.
Противогрибковые препараты46. Противогрибковые препараты
• Значительная часть противогрибковых препаратов направлена на подавлениесинтеза эргостерола – специфического компонента мембран грибов,
который регулирует текучесть билипидного слоя аналогично холестерину
человека.
• Азолы (флуконазол, итраконазол, клотримазол, миконазол, кетоконазол,)
ингибируют ланостерол-14-α-деметилазу,
• Аллиламины (нафтифин, тербинафин) подавляют
работу сквален-эпоксидазы.
• Полиены – это группа природных противогрибковых веществ, механизм
действия которых связан с нарушением целостности цитоплазматической
мембраны.
• Они встраиваются в неё, образуя комплекс с молекулами эргостерола, что
приводит к образованию поры, проницаемой для ионов.
• Представителями полиенов являются нистатин, натамицин и
амфотерицин B.
47. Противогрибковые препараты
• Эхинокандины• – относительно новая группа полусинтетических
противогрибковых препаратов,
• - механизм действия связан с ингибировниаем 1,3-β-глюкансинтазы – фермента, который участвует в построении
клеточной стенки грибов.
• Примерами эхинокандинов являются каспофунгин,
микафунгин, анидулафунгин.
• Также в качестве противогрибковых препаратов иногда
используются гризеофульвин (нарушающий работу
микротрубочек) и
• фторцитозин (аналог азотистого основания, нарушающий
синтез нуклеиновых кислот).
48. Антимикробные пептиды
• принципиально новый класс природных антибиотиков• относительно короткие молекулы (в среднем порядка 30–40 аминокислот),
способные убивать клетки микроорганизмов.
задействованы в системе врожденного иммунитета.
охарактеризовано более 800 таких пептидов: молекулы из многих тканей
и типов клеток беспозвоночных, позвоночных, растений и грибов; некоторые
хемокины, цитокины, нейропептиды, нейрогормоны и фрагменты белков.
ряд пептидов производится собственно микроогранизмами.
Например, Lactococcus casea, молочнокислые бактерии — популярная
добавка ко всяким «иммунизирующим» йогуртам, — продуцируют
высокоактивный пептид низин.
Выделяют два основных типа воздействия антимикробных пептидов
на клетки: ингибирование метаболитических процессов или нарушение
целостности клеточной мембраны.
Большинство антимикробных пептидов вызывают гибель клетки по второму
механизму.
Лишь для некоторых пептидов показано действие по первому типу, среди них
лантибиотики, которые селективно связываются с предшественником
бактериальной стенки
49. Антимикробные пептиды
Антимикробные пептиды можно разделить на несколькогрупп:
1. линейные α-спиральные пептиды (напр., магаинин,
меллитин, цекропин);
2. пептиды, богатые определенной аминокислотой,
напр., гистидином или пролином;
3. пептиды, имеющие сложную пространственную
организацию, содержащие дисульфидные мостики,
тиоэфирные циклы и др. К ним относятся
дефензины, протегрины и лантибиотики —
высокоактивные бактериальные пептиды (напр.,
низин — см. выше).
Для большинства таких пептидов характерно несколько общих черт:
высокий положительный заряд (+2 ÷ +9), пространственное разделение
гидрофобных и гидрофильных участков молекулы (амфифильность).
Амфифильность является важной особенностью антимикробных пептидов,
которая обеспечивает возможность одновременно выгодно взаимодействовать
с гидрофобным ядром липидной мембраны и полярным окружением (например,
с водой).
50. Антимикробные пептиды
• антимикробные пептиды обладаютцитотоксическим эффектом (действуют
на эукариотические клетки),
• наиболее эффективно они могут быть
использованы при лечении заболеваний
наружных покровов, слизистых — без введения
в кровь пациента.
• циклический пептидный антибиотик рамопланин
уже находится на стадии клинических испытаний
для лечения инфекционных заболеваний
дыхательных путей.
• показано, что ингаляции смеси, содержащей
антимикробные пептиды, являются эффективными
в терапии туберкулеза.
Антимикробный пептид
рамопланин (Ramoplanin).
Продукт нерибосомального
синтеза в грибах
рода Actinomycetes spp.
Механизм действия основан
на связывании
с предшественником
бактериальной стенки
липидом II.
51.
• Немецкий исследователь Александр Ципперер со своими сотрудникамив июле 2016 года сообщил о том, что обнаружил в человеческом носу
бактерию Staphylococcus lugdunensisIVK28, которая подавляет рост
метициллин-резистентного золотистого стафилококка (methicillin-resistant
Staphylococcus aureus, MRSA)
• В итоге удалось получить мутанта IVK28, который не мог подавлять рост
MRSA. Анализ места встройки транспозона показал, что тот нарушил
структуру гена предполагаемойнерибосомной пептидсинтетазы (НРПС).
Оказалось, что этот ген вместе с другими последовательностями, связанными
с биосинтезом антибиотиков, входит в состав оперона размером 30 т.п.н. Это
указывало на то, что предполагаемая молекула ингибитора может быть
комплексом нерибосомных пептидов.
• Выделенный Ципперером продукт lug-оперона
оказался нерибосомным циклическим пептидом, состоящим из пяти
аминокислот (двух D-валинов, L-валина, D-лейцина и L-триптофана)
и тиазолидинового гетероцикла (рис. 4). Назвали
антибиотик лугдунином.
52. Нерибосомные пептиды
• Этот класс пептидов синтезируется в клетках низших грибов и бактерий без участиярибосом. Нерибосомные пептиды (НРП) также встречаются и у высших организмов,
которые имеют бактерий-комменсалов [12].
НРП подразделяются на несколько функциональных групп [13]:
антибиотики (ванкомицин);
предшественники антибиотиков (ACV-трипептид — предшественник пенициллина
и цефалоспорина);
иммуносупрессоры (циклоспорин);
противоопухолевые пептиды (блеомицин);
сидерофоры (пиовердин);
токсины (HC-токсин);
сурфактанты (сурфактин).
Строение
Нерибосомные пептиды имеют длину от 2 до 50 аминокислот и часто циклическую
или разветвленную структуру. Они содержат как «обычные», протеиногенные, так
и непротеиногенные аминокислоты — D-формы или остатки, модифицированные
присоединением N-метильных и N-формильных групп, гликозилированием,
гидроксилированием, ацилированием или галогенированием. Циклизация
происходит путем образования в пептидном остове оксазолинов и тиазолинов [12].
53.
• Синтез• НРП синтезируются нерибосомными пептидсинтетазами (НРПС), которые в своей
работе не следуют «чужим» инструкциям, то есть обходятся без мРНК. НРПС — это
гигантские мультимодульные ферменты, каждый из которых может синтезировать
только один вид пептидов. Отдельный модуль фермента отвечает за включение
одной аминокислоты в пептидную цепь, поэтому количество модулей соответствует
длине пептида [14].
Каждый модуль состоит как минимум из трех доменов:
конденсирующего (принимающего пептидную цепь из предыдущего модуля);
аденилирующего (выбирающего нужную аминокислоту);
пептидильного (образующего пептидную связь).
Нередко модули включают и другие домены, в том числе эпимеризующий, который
преобразует L-аминокислоты в D-формы [14].
По аналогии с триплетным рибосомным кодом для синтеза белка существует
и нерибосомный, код НРПС, определяемый 10 остатками аминокислот в субстратсвязывающем кармане аденилирующего домена. От комбинации этих остатков
зависит то, какая аминокислота будет встроена в пептид конкретным модулем НРПС.
Зная этот код, можно предсказывать субстратную специфичность аденилирующих
доменов и даже произвольно изменять ее посредством замены аминокислот
в домене [14].
54. Лекарственная устойчивость
• Лекарственная устойчивостьмикроорганизмов — способность
микроорганизмов сохранять
жизнедеятельность, включая размножение,
несмотря на контакт с химиопрепаратами.
• Различают лекарственную устойчивость,
природно присущую микроорганизмам и
возникшую в результате мутаций или
приобретения чужеродных генов.
55.
56.
57.
Механизмылекарственной
устойчивости
Инактивация антибиотика превращением активной формы в
неактивную путем ферментативного разршения и/или
модификации;
Утрата проницаемости клеточной стенки для определенного
химиотерапевтического препарата;
Нарушения в системе специфического транспорта данного
препарата в бактериальную клетку;
Активное выведение антибиотика из микробной клетки
(эффлюкс).
58.
Формирование метаболического «шунта» : возникновением умикроорганизмов альтернативного пути образования жизненно
важного метаболита (продукта метаболизма), заменяющего
основной путь, блокированный препаратом.
Изменение конформации внутриклеточной мишени для
антимикробного агента, что препятствует его взаимодействию с
мишенью,
Образованием повышенного количества молекул мишени, на
которую действует данный антимикробный агент.
59. Ферментная инактивация антимикробных препаратов.
В качестве инактивирующих ферментов известныпредставители гидролаз:
бета-лактамазы, катализирующие расщепление бета-лактамного
кольца у пенициллинов, цефалоспоринов и других беталактамов (монобактамов, карбапенемов и т.д.),
эстеразы, воздействующие на эритромицин и некоторые другие
антибиотики близкой к нему структуры.
Другая группа инактивирующих ферментов — трансферазы. К
ним принадлежат левомицетин- (хлорамфеникол-)ацетилтрансферазы, аминогликозидацетил, фосфо- или
аденилилтрансферазы и фосфотрансферазы, воздействующие
на эритромицин
60.
Ферментная инактивация антимикробныхпрепаратов.
β-лактамазы, продуцируемые грам + бактериями выделяются
из клетки в межклеточное пространство, а продуцируемые грам
-бактериями не покидают клетку и циркулируют между
наружной и внутренней мембранами.
Все известные в настоящее время β-лактамазы делят на 4
молекулярных класса, в пределах которых ферменты
характеризуются общностью свойств и выраженной гомологией.
61. β-лактамазы
В настоящее время наибольшее значение для клиническойпрактики имеют плазмидные β - лактамазы расширенного
спектра грамотрицательных бактерий (БЛРС), поскольку они
способны разрушать цефалоспорины III и, в меньшей
степени, IV поколения.
Рутинные методы оценки антибиотикочувствительности
очень часто не выявляют этот механизм устойчивости.
Чаще всего БЛРС встречаются у микроорганизмов рода
Klebsiella, достаточно часто у E.coli и Proteus spp., реже у
других грамотрицательных бактерий.
В России в отдельных учреждениях частота
распространенности этих ферментов среди клебсиелл
достигает 90%.
62.
63. Определение бета-лактамазной активности
• Среда с пенициллином и индикатором фенолрот послеинкубирования с чистой культурой бактерий.
• Под действием бета-лактамазы пенициллин превращается
в кислоту и исходный красный цвет индикатора меняется
на желтый
• Желтый цвет –положительный результат,
• Красный - отрицательный
64.
Различные фенотипические методы, применяемые в настоящеевремя для обнаружения продукции БЛРС, основаны на эффекте
подавления их активности в присутствии клавулановой кислоты.
Метод "двойных дисков"
Принцип
Метод "двойных дисков" представляет собой вариант
классического дискодиффузионного метода определения
чувствительности, который позволяет обнаружить продукцию
БЛРС по наличию расширенной зоны подавления роста вокруг
диска с цефалоспорином III поколения напротив диска,
содержащего клавулановую кислоту (синергизм отмечается в
участке пересечения зон диффузии двух дисков, расположенных
на небольшом расстоянии друг от друга).
1 – цефотаксим
2 – амоксицилин/клавулановая кислота
1
2
65.
Метод E-тестовПринцип
• Е-тесты представляют собой пластиковые полоски, на
внутренней (обращенной к агару) стороне которых нанесен
антибиотик в заданном градиенте концентрации, а на внешней
стороне – шкала соответствующих значений МПК.
• Е-тесты, используемые для выявления БЛРС, содержат на
противоположных концах полоски два убывающих по
направлению к центру градиента концентрации: цефтазидима и
комбинации цефтазидима с клавулановой кислотой, нанесенной
в фиксированной концентрации вдоль градиента
a - E.coli , отрицательный результат
b - E.coli , положительный результат
66. Ингибиторы бета-лактамаз
Ингибиторы бета-лактамаз представляют собой бета-лактамные структуры,которые необратимо связываются с ферментами, сами при этом разрушаясь,
вследствие чего они получили название суицидных ингибиторов.
В настоящее время клиническое значение имеют три таких ингибитора:
клавулановая кислота (клавуланат) и два производных пенициллановой кислоты
— сульбактам и тазобактам.
Они входят в состав комбинированных препаратов, содержащих
пенициллиновый антибиотик (ампициллин, амоксициллин, пиперациллин,
тикарциллин) и один из ингибиторов β-лактамаз. Такие препараты получили
название ингибиторозащищенных пенициллинов
(АМОКСИЦИЛЛИН/КЛАВУЛАНАТ (КО-АМОКСИКЛАВ)=Аугментин, Амоксиклав;
АМПИЦИЛЛИН/СУЛЬБАКТАМ=Уназин, Сулациллин;
ТИКАРЦИЛЛИН/КЛАВУЛАНАТ=Тиментин;
ПИПЕРАЦИЛЛИН/ТАЗОБАКТАМ=Тазоцин
Применяется также комбинация цефалоспорина III поколения цефоперазона с
сульбактамом (сульперазон).
67. Примеры комбинированных препаратов
Сультамициллин:двойной эфир
ампициллина (полусинтетического
пенициллина) и сульбактама
(ингибитора бета-лактамаз).
Действует бактерицидно.
АМОКСИЦИЛЛИН (AMOXICILLIN); КЛАВУЛАНОВАЯ КИСЛОТА
68. Принцип диско-диффузионного метода определения чувствительности к антибиотикам
Бактериальную культуру засеваютгазоном на питательный агар, после чего на
его поверхность пинцетом помещают на
равномерном расстоянии друг от друга
бумажные диски, содержащие
определенные дозы разных антибиотиков.
Посевы инкубируют при 37 0 С в течение
суток. По диаметру зон задержки роста
культуры судят о ее чувствительности к
соответствующим антибиотикам. При зоне
задержки роста до 15 мм культура
расценивается как нечувствительная или
низко чувствительная, 15 – 24 мм – средняя
чувствительность, 25 мм и более –
высокочувствительная.
69. Ход исследования:
• Приготовить взвесь чистой культуры м/о• Сравнить с 0,5 по Мак –Фарленду (стандарт мутности взвеси бактерий)
• Чашку со средой Мюллер- Хинтона засеять ЧК
• Уложить диски не более 6
Инкубировать в термостате 18 – 24 часа
• Прочесть и зафиксировать результат
70. Работа с диспенсером
Быстрее и удобнее использовать диспенсердля дисков
71. Работа с диспенсером
72. Чтение результатов
73.
74. Октодиски
75.
• Измерение зон ингибированияантибиотиками ProtoCOL2 Zone
Функциональные возможности:
- Определение чувствительности
бактерий к антибиотикам (измерение зон
ингибиции роста штамма вокруг диска с
антибиотиком)
- Автоматический учет результатов
- Архивирование данных
- Выдача результатов на бланке
- Автоматическое определение зон
ингибиции роста тест - штамма при
изучении активности антибиотиков в
сырье, фарм. препаратах, а также
биологически активных веществ на
стадии доклинических испытаний
- Автоматический анализ результатов
(замер диаметров зон преципитации)
при исследовании иммуноглобулинов
методом радиальной иммунодиффузии
(по Манчини).
- Автоматический пересчет числа
колоний бактерий с учетом разведения
пробы
76. Определение чувствительности к антибиотикам методом серийных разведений.
Пробирка с видимымотсутствием роста бактерий
при наименьшей
концентрации антибиотика –
МИК(МПК) – минимальная
ингибирующая концентрация
МИК(МПК) и МБК – критерии активности
антибиотика
При посеве материала из
пробирок с видимым
отсутствием роста бактерий на
питательные среды
обнаруживается рост колоний
При посеве из пробирки с
концентрацией 25 мкг/мл
рост бактерий отсутствует –
МБК- минимальная
бактерицидная концентрация
антибиотика
77. Автоматизированные методы
Cовременные полностью автоматические анализаторы,разработанные для автоматизации и стандартизации
процесса микробиологического анализа:
1.Идентификация микроорганизмов
2.Определение чувствительности к антибиотикам
3. Статистическая обработка и стандартизация
результатов микробиологического исследования
78. Чувствительность к АМП на стрипах ATB.
Стрипы ATB предназначены для полуколичественного определениячувствительности к антимикробным препаратам в полужидкой среде.
Стрип состоит из 16 или 32 лунок.
В лунках содержатся антимикробные препараты в одной или двух
концентрациях.
Определение чувствительности к 15-30 препаратам на одном стрипе.
Визуальный учет результатов по наличию / отсутствию роста в лунках.















































































 Медицина
Медицина